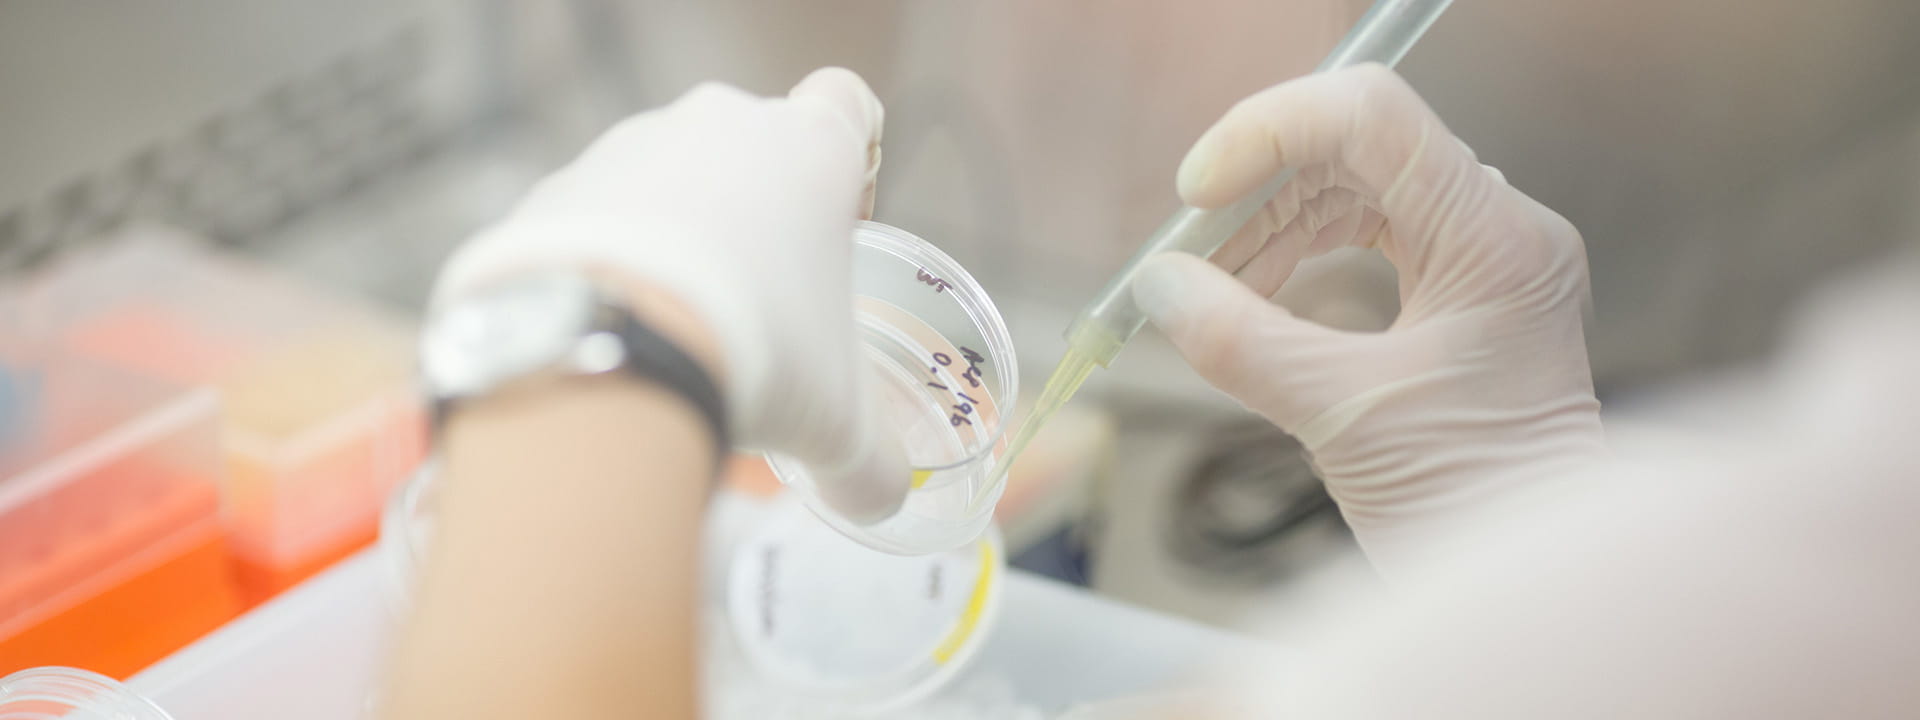

Our IU School of Medicine donors are our champions. They are a source of inspiration, motivation, and empowerment to prepare compassionate healers and pursue bold research that transforms health. Our donors are the fuel that makes better health a reality for Hoosiers and patients everywhere.
Generosity–at all levels–is what makes our mission come alive.
Our donors’ support of our students goes beyond making medical school more affordable. It recruits and rewards the physicians who will go on to serve thousands of patients–patients that are our friends, family, and neighbors.
Our donors drive innovation and groundbreaking research. Generosity nurtures bold ideas in the earliest stages of development, which then helps us reimagine how we prevent, detect, and cure debilitating diseases.